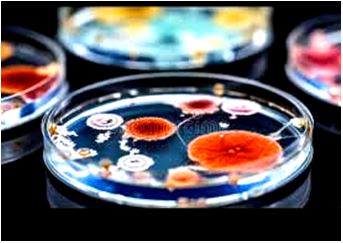

EXPLORING VARIABILITY IN COMPLEX SYSTEMS: A SYNTHESIS OF MICROBIOLOGICAL ENVIRONMENTAL MONITORING, EPIDEMIOLOGICAL TRENDING, AND QUANTITATIVE BIOLOGICAL THEORIES
Keywords:
Biological variability, pharmaceutical microbiology, public health epidemiology, quantitative risk assessment, systems biology, statistical process controlAbstract
The advancement of pharmaceutical sciences and public health is fundamentally constrained by our capacity to distinguish meaningful signals from inherent noise within complex, non-linear biological systems. Variability is an omnipresent characteristic of biological data, manifesting as fluctuating bioburden in pharmaceutical water systems, unpredictable waves of infectious disease outbreaks, and stochastic molecular interactions. This exploratory theoretical review synthesizes transdisciplinary research to bridge the conceptual gaps between industrial quality control, global epidemiology, and advanced theoretical frameworks. Moreover, we critically evaluate the application of Statistical Process Control (SPC) and Quantitative Risk Assessment (QRA) as robust methodologies for managing variability across vastly different scales. From the micro-scale challenges of validating disinfection efficacy against resistant microbial spores to the macro-scale patterns of COVID-19 morbidity and the emerging insights from quantitative biology, this manuscript posits that a unified analytical framework is not only beneficial but necessary. Thus, it is argued that chaotic variability in life sciences is not merely random error but often follows decipherable statistical patterns and emergent laws. A deeper understanding of these patterns enables superior predictive modeling, enhanced process control, and more resilient public health interventions. At the end, this synthesis aims to provide for a more integrated, data-driven approach to quality and health in the 21st century.
Peer Review History:
Received 11 October 2025; Reviewed 17 November 2025; Accepted 24 December; Available online 15 January 2026
Academic Editor: Dr. Jennifer Audu-Peter , University of Jos, Nigeria, drambia44@gmail.com
, University of Jos, Nigeria, drambia44@gmail.com
Reviewers:
 Dr. Rana Ahmed MohamedEl-Saied El-Fitiany, Ahram Canadian University, Giza, Egypt, marmarelfitiany@gmail.com
Dr. Rana Ahmed MohamedEl-Saied El-Fitiany, Ahram Canadian University, Giza, Egypt, marmarelfitiany@gmail.com
 Dr. Poualeu Kamani Sylviane Laure, University of Dschang, Cameroon, poualeusylviane@yahoo.fr
Dr. Poualeu Kamani Sylviane Laure, University of Dschang, Cameroon, poualeusylviane@yahoo.fr
Downloads

Published
How to Cite
Issue
Section
Copyright (c) 2026 Universal Journal of Pharmaceutical Research

This work is licensed under a Creative Commons Attribution-NonCommercial 4.0 International License.









 .
.